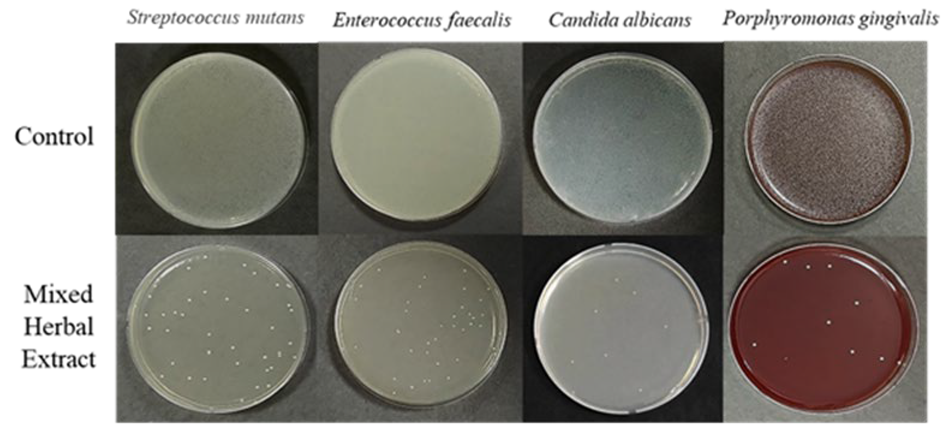
Medicina 59 01771 g001

Antimicrobial Effects of Edible Mixed Herbal Extracts on Oral Microorganisms: An In Vitro Study
Abstract
:1. Introduction
2. Materials and Methods
2.1. Herbal Extracts
2.2. Test Strains and Culture Conditions
2.3. Antimicrobial Efficacy of Mixed Herbal Extracts
2.4. Morphological Examination of Oral Pathogens via Scanning Electron Microscopy
2.5. Microbial Surface Hydrophobicity
2.6. Oral Malodor Reduction
2.7. Data Analysis
3. Results
3.1. Inhibitory Effects of Mixed Herbal Extracts on Oral Pathogens
3.2. Morphological Examination of Oral Pathogens
3.3. Bacterial Surface Hydrophobicity
3.4. Measurement of VSCs
4. Discussion
5. Conclusions
Author Contributions
Funding
Institutional Review Board Statement
Informed Consent Statement
Data Availability Statement
Conflicts of Interest
References
- Bumm, C.V.; Folwaczny, M.; Stokes, L.N.; Olsen, I.; Dewhirst, F.E. Infective endocarditis and oral health—A Narrative Review. Cardivasc. Diagn. Ther. 2021, 11, 1403–1415. [Google Scholar] [CrossRef]
- Toz Ertop, M.; Cicek, O.; Erener, H.; Ozkalayci, N.; Demir Cicek, B.; Comert, F. Evaluation of the Demineralization Development around Different Types of Orthodontic Brackets. Materials 2023, 16, 984. [Google Scholar] [CrossRef]
- Huang, R.; Li, M.; Gregory, R.L. Bacterial interactions in dental biofilm. Virulence 2011, 2, 435–444. [Google Scholar] [CrossRef] [PubMed]
- Chen, X.; Daliri, E.B.; Tyagi, A.; Oh, D.H. Cariogenic Biofilm: Pathology-Related Phenotypes and Targeted Therapy. Microorganisms 2021, 9, 1311. [Google Scholar] [CrossRef]
- Rajendra Santosh, A.B.; Muddana, K.; Bakki, S.R. Fungal Infections of Oral Cavity: Diagnosis, Management, and Association with COVID-19. SN Compr. Clin. Med. 2021, 3, 1373–1384. [Google Scholar] [CrossRef] [PubMed]
- Bui, F.Q.; Almeida-da-Silva, C.L.C.; Huynh, B.; Trinh, A.; Liu, J.; Woodward, J.; Asadi, H.; Ojcius, D.M. Association between periodontal pathogens and systemic disease. Biomed. J. 2019, 42, 27–35. [Google Scholar] [CrossRef] [PubMed]
- Grover, V.; Mahendra, J.; Gopalakrishnan, D.; Jain, A. Effect of octenidine mouthwash on plaque, gingivitis, and oral microbial growth: A systematic review. Clin. Exp. Dent. Res. 2021, 7, 450–464. [Google Scholar] [CrossRef]
- Katsura, H.; Tsukiyama, R.I.; Suzuki, A.; Kobayashi, M. In vitro antimicrobial activities of bakuchiol against oral microorganism. Antimicrob. Agents Chemother. 2001, 45, 3009–3013. [Google Scholar] [CrossRef]
- Inhartová, L.; Michalíková, K.; Šrédlová, K.; Cajthaml, T. Biodegradability of Dental Care Antimicrobial Agents Chlorhexidine and Octenidine by Ligninolytic Fungi. Molecules 2020, 25, 400. [Google Scholar] [CrossRef] [PubMed]
- Pytko-Polończyk, J.; Stawarz-Janeczek, M.; Kryczyk-Poprawa, A.; Muszyńska, B. Antioxidant-Rich Natural Raw Materials in the Prevention and Treatment of Selected Oral Cavity and Periodontal Diseases. Antioxidants 2021, 10, 1848. [Google Scholar] [CrossRef] [PubMed]
- Schönknecht, K.; Surdacka, A.; Rudenko, L.; Scherer, W. Effectiveness of composed herbal extract in the treatment of gingivitis and oral and pharyngeal mucosa—Review of studies. Wiad. Lek. 2021, 74, 1737–1749. [Google Scholar] [CrossRef]
- Kováč, J.; Slobodníková, L.; Trajčíková, E.; Rendeková, K.; Mučaji, P.; Sychrová, A.; Bittner Fialová, S. Therapeutic Potential of Flavonoids and Tannins in Management of Oral Infectious Diseases–A Review. Molecules 2022, 28, 158. [Google Scholar] [CrossRef] [PubMed]
- Lin, Z.; Gan, T.; Huang, Y.; Bao, L.; Liu, S.; Cui, X.; Wang, H.; Jiao, F.; Zhang, M.; Su, C.; et al. Anti-Inflammatory Activity of Mulberry Leaf Flavonoids In Vitro and In Vivo. Int. J. Mol. Sci. 2022, 23, 7694. [Google Scholar] [CrossRef] [PubMed]
- Vyas, T.; Nagi, R.; Bhatia, A.; Bains, S.K. Therapeutic effects of green tea as an antioxidant on oral health—A review. J. Fam. Med. Prim. Care 2021, 10, 3998–4001. [Google Scholar] [CrossRef]
- Takasago, K. Addition of cariogenic pathogens to complex oral microflora drives significant changes in biofilm compositions and functionalities. Microbiome 2023, 11, 123. [Google Scholar] [CrossRef]
- Chen, S.G.; Cheng, M.L.; Chen, K.H.; Horng, J.T.; Liu, C.C.; Wang, S.M.; Sakurai, H.; Leu, Y.L.; Wang, S.D.; Ho, H.Y. Antiviral activities of Schizonepeta tenuifolia Briq. against enterovirus 71 in vitro and in vivo. Sci. Rep. 2017, 7, 935. [Google Scholar] [CrossRef]
- Nadeem, A.; Shahzad, H.; Ahmed, B.; Muntean, T.; Waseem, M.; Tabassum, A. Phytochemical profiling of antimicrobial and potential antioxidant plant: Nepeta cataria. Front. Plant Sci. 2022, 13, 969316. [Google Scholar] [CrossRef]
- Dolghi, A.; Coricovac, D.; Dinu, S.; Pinzaru, I.; Dehelean, C.A.; Grosu, C.; Chioran, D.; Merghes, P.E.; Sarau, C.A. Essential Oils and In Vitro Potential Cytotoxic Effect in Human Colorectal Carcinoma Cells. Molecules 2022, 27, 6106. [Google Scholar] [CrossRef]
- Sim, L.Y.; Abd Rani, N.Z.; Husain, K. Lamiaceae: An Insight on Their Anti-Allergic Potential and Its Mechanisms of Action. Front. Pharmacol. 2019, 10, 677. [Google Scholar] [CrossRef]
- Aebisher, D.; Cichonski, J.; Szpyrka, E.; Masjonis, S.; Chrzanowski, G. Essential Oils of Seven Lamiaceae Plants and Their Antioxidant Capacity. Molecules 2021, 26, 3793. [Google Scholar] [CrossRef]
- Uritu, C.M.; Mihai, C.T.; Stanciu, G.D.; Dodi, G.; Alexa-Stratulat, T.; Luca, A.; Leon-Constantin, M.M.; Stefanescu, R.; Bild, V.; Melnic, S.; et al. Medicinal Plants of the Family Lamiaceae in Pain Therapy: A Review. Pain Res. Manag. 2018, 2018, 7801543. [Google Scholar] [CrossRef]
- Bae, E.A.; Yook, C.S.; Oh, O.J.; Chang, S.Y.; Nohara, T.; Kim, D.H. Metabolism of chiisanoside from Acanthopanax divaricatus var. albeofructus by human intestinal bacteria and its relation to some biological activities. Biol. Pharm. Bull. 2001, 24, 582–585. [Google Scholar] [CrossRef]
- Bian, X.; Zhao, Y.; Guo, X.; Zhang, L.; Li, P.; Fu, T.; Wang, W.; Yin, Y.; Chen, G.; Liu, J. Chiisanoside, a triterpenoid saponin, exhibits anti-tumor activity by promoting apoptosis and inhibiting angiogenesis. RSC Adv. 1996, 19, 41640–41650. [Google Scholar] [CrossRef]
- Bian, X.; Liu, X.; Liu, J.; Zhao, Y.; Li, H.; Zhang, L.; Li, P.; Gao, Y. Hepatoprotective effect of chiisanoside from Acanthopanax sessiliflorus against LPS/D-GalN-induced acute liver injury by inhibiting NF-κB and activating Nrf2/HO-1 signaling pathways. J. Sci. Food Agric. 2019, 99, 3283–3290. [Google Scholar] [CrossRef]
- Hu, C.; Liu, H.; Du, J.; Mo, B.; Qi, H.; Wang, X.; Ye, S.; Li, Z. Estrogenic activities of extracts of Chinese licorice (Glycyrrhiza uralensis) root in MCF-7 breast cancer cells. J. Steroid Biochem. Mol. Biol. 2009, 113, 209–216. [Google Scholar] [CrossRef]
- Tanaka, Y.; Kikuzaki, H.; Fukuda, S.; Nakatani, N. Antimicrobial compounds of licorice against upper airway respiratory tract pathogens. J. Nutr. Sci. Vitaminol. 2001, 47, 270–273. [Google Scholar] [CrossRef] [PubMed]
- Choi, B.B.; Choi, J.H.; Park, S.R.; Kim, J.Y.; Hong, J.W.; Kim, G.C. Scutellariae radix induces apoptosis in chemoresistant SCC-25 human tongue squamous carcinoma cells. Am. J. Chin. Med. 2015, 43, 167–181. [Google Scholar] [CrossRef] [PubMed]
- Park, N.S.; Yun, S.E.; Lee, H.Y.; Lee, H.J.; Choi, J.H.; Kim, G.C. No-ozone cold plasma can kill oral pathogenic microbes in H2O2-dependent and independent manner. Sci. Rep. 2022, 12, 7597. [Google Scholar] [CrossRef]
- Golding, C.G.; Lamboo, L.L.; Beniac, D.R.; Booth, T.F. The scanning electron microscope in microbiology and diagnosis of infectious disease. Sci. Rep. 2016, 23, 26516. [Google Scholar] [CrossRef]
- Lather, P.; Mohanty, A.K.; Jha, P.; Garsa, A.K. Contribution of Cell Surface Hydrophobicity in the Resistance of Staphylococcus aureus against Antimicrobial Agents. Biochem. Res. Int. 2016, 2016, 1091290. [Google Scholar] [CrossRef]
- Li, F.; Wang, C.; Xu, J.; Wang, X.; Cao, M.; Wang, S.; Zhang, T.; Xu, Y.; Wang, J.; Pan, S.; et al. Evaluation of the antibacterial activity of Elsholtzia ciliate essential oil against halitosis-related Fusobacterium nucleatum and Porphyromonas gingivalis. Front. Microbiol. 2023, 14, 1219004. [Google Scholar] [CrossRef] [PubMed]
- IBM Corp. IBM SPSS Statistics for Windows, Version 24.0; IBM Corp.: Armonk, NY, USA, 2016. [Google Scholar]
- Demircioglu, R.M.; Cicek, O.; Comert, F.; Erener, H. Do Different Types of Adhesive Agents Effect Enamel Demineralization for Orthodontic Bonding? An In Vitro Study. Coatings 2023, 13, 401. [Google Scholar] [CrossRef]
- Forssten, S.D.; Björklund, M.; Ouwehand, A.C. Streptococcus mutans, caries and simulation models. Nutrients 2010, 2, 290–298. [Google Scholar] [CrossRef]
- Komiyama, E.Y.; Lepesqueur, L.S.; Yassuda, C.G.; Samaranayake, L.P.; Parahitiyawa, N.B.; Balducci, I.; Koga-Ito, C.Y. Enterococcus Species in the Oral Cavity: Prevalence, Virulence Factors and Antimicrobial Susceptibility. PLoS ONE 2016, 11, e0163001. [Google Scholar] [CrossRef]
- Du, Q.; Ren, B.; He, J.; Peng, X.; Guo, Q.; Zheng, L.; Li, J.; Dai, H.; Chen, V.; Zhang, L.; et al. Candida albicans promotes tooth decay by inducing oral microbial dysbiosis. ISME J. 2021, 15, 894–908. [Google Scholar] [CrossRef]
- Carrol, D.H.; Chassagne, F.; Dettweiler, M.; Quave, C.L. Antibacterial activity of plant species used for oral health against Porphyromonas gingivalis. PLoS ONE 2020, 15, e0239316. [Google Scholar] [CrossRef]
- Baker, P.J.; Coburn, R.A.; Genco, R.J.; Evans, R.T. The in vitro inhibition of microbial growth and plaque formation by surfactant drugs. J. Periodontal Res. 1978, 13, 474–485. [Google Scholar] [CrossRef]
- Vergara-Buenaventura, A.; Castro-Ruiz, C. Use of mouthwashes against COVID-19 in dentistry. Br. J. Oral Maxillofac. Surg. 2020, 58, 924–927. [Google Scholar] [CrossRef]
- Palombo, E.A. Traditional Medicinal Plant Extracts and Natural Products with Activity against Oral Bacteria: Potential Application in the Prevention and Treatment of Oral Diseases. Evid. Based Complement. Altern. Med. 2011, 2011, 680354. [Google Scholar] [CrossRef] [PubMed]
- James, P.; Worthington, H.V.; Parnell, C.; Harding, M.; Lamont, T.; Cheung, A.; Whelton, H.; Riley, P. Chlorhexidine mouthrinse as an adjunctive treatment for gingival health. Cochrane Database Syst. Rev. 2017, 3, CD008676. [Google Scholar] [CrossRef]
- McCullough, M.J.; Farah, C.S. The role of alcohol in oral carcinogenesis with particular reference to alcohol-containing mouthwashes. Aust. Dent. J. 2008, 53, 302–305. [Google Scholar] [CrossRef]
- Zhao, X.; Zhou, M. Review on Chemical Constituents of Schizonepeta tenuifolia Briq. and Their Pharmacological Effects. Molecules 2022, 27, 5249. [Google Scholar] [CrossRef]
- Fukai, T.; Marumo, A.; Kaitou, K.; Kanda, T.; Terada, S.; Nomura, T. Anti-Helicobacter pylori flavonoids from licorice extract. Life Sci. 2002, 2002, 1449–1463. [Google Scholar] [CrossRef]
- Asl, M.N.; Hosseinzadeh, H. Review of pharmacological effects of Glycyrrhiza sp. and its bioactive compounds. Phytother. Res. 2008, 22, 709–724. [Google Scholar] [CrossRef]
- Wen, D.; Liu, Y.; Li, W.; Liu, H. Separation methods for antimicrobial and antirheumatism agents in plant medicines. J. Chromatogr. B Analyt. Technol. Biomed. Life Sci. 2004, 812, 101–117. [Google Scholar] [CrossRef] [PubMed]
- Størmer, F.C.; Reistad, R.; Alexander, J. Glycyrrhizic acid in liquorice—Evaluation of health hazard. Food Chem. Toxicol. 1993, 31, 303–312. [Google Scholar] [CrossRef] [PubMed]
- Koohsari, H.; Ghaemi, E.A.; Sadegh Sheshpoli, M.; Jahedi, M.; Zahiri, M. The investigation of antibacterial activity of selected native plants from North of Iran. J. Med. Life 2015, 8, 38–42. [Google Scholar] [PubMed]
- Sangetha, S.; Zuraini, Z.; Sasidharan, S.; Suryani, S. Fungicidal effect and oral acute toxicity of Cassia spectabilis leaf extract. Nihon Ishinkin Gakkai Zasshi 2008, 49, 299–304. [Google Scholar] [CrossRef] [PubMed]
- Meurman, J.H. Ultrastructure, growth, and adherence of Streptococcus mutans after treatment with chlorhexidine and fluoride. Caries Res. 1988, 22, 283–287. [Google Scholar] [CrossRef]
- Dong, L.; Tong, Z.; Linghu, D.; Lin, Y.; Tao, R.; Liu, J.; Tian, Y.; Ni, L. Effects of sub-minimum inhibitory concentrations of antimicrobial agents on Streptococcus mutans biofilm formation. Int. J. Antimicrob. Agents 2012, 39, 390–395. [Google Scholar] [CrossRef]
- Izidoro, C.; Botelho, J.; Machado, V.; Reis, A.M.; Proença, L.; Alves, R.C.; Mendes, J.J. Revisiting Standard and Novel Therapeutic Approaches in Halitosis: A Review. Int. J. Environ. Res. Public Health 2022, 19, 11303. [Google Scholar] [CrossRef] [PubMed]
- Morita, M.; Wang, H.L. Relationship of sulcular sulfide level and oral malodor in subjects with periodontal disease. J. Periodontol. 2001, 72, 79–84. [Google Scholar] [CrossRef]
- Yoo, H.J.; Jwa, S.K.; Kim, D.H.; Ji, Y.J. Inhibitory effect of Streptococcus salivarius K12 and M18 on halitosis in vitro. Clin. Exp. Dent. Res. 2020, 6, 207–214. [Google Scholar] [CrossRef] [PubMed]
- Suzuki, N.; Yoneda, M.; Takeshita, T.; Hirofuji, T.; Hanioka, T. Induction and inhibition of oral malodor. Mol. Oral Microbiol. 2019, 34, 85–96. [Google Scholar] [CrossRef] [PubMed]

| Scientific Name | Plant Part | Concentration (mg/mL) |
|---|---|---|
| Schizonepeta tenuifolia | Above-ground | 0.5 |
| Mentha piperascens | Leaf | 1.5 |
| Acanthopanax sessiliflorus Seem | Bark | 1.5 |
| Glycyrrhiza uralensis | Root | 2 |
| Strains | Straining Property | Culture Requirement | Media |
|---|---|---|---|
| S. mutans a (KCTC b3065) | Gram-positive | Facultative anaerobic | Brain heart infusion/agar |
| E. faecalis c (KCTC2011) | Gram-positive | Facultative anaerobic | Brain heart infusion/agar |
| C. albicans d (KCTC7965) | Gram-positive | Aerobic | YM broth/agar |
| P. gingivalis e (KCTC5352) | Gram-negative | Anaerobic | Tryptic soy broth/agar |
| Group | S. mutans a | E. faecalis b | C. albicans c | P. gingivalis d |
|---|---|---|---|---|
| Control | 5.90 ± 0.01 | 5.95 ± 0.01 | 5.85 ± 0.02 | 5.74 ± 0.01 |
| Mixed herbal extracts | 1.48 ± 0.03 ** | 1.49 ± 0.05 ** | 0.90 ± 0.03 ** | 0.95 ± 0.03 ** |
| Group | S. mutans a | E. faecalis b | C. albicans c | P. gingivalis d |
|---|---|---|---|---|
| Control | 100 | 100 | 100 | 100 |
| 1 min e | 61.20 ± 3.20 ** | 85.63 ± 3.70 * | 80.89 ±1.17 * | 44.11 ± 2.10 * |
| 3 min e | 60.37 ± 0.73 * | 83.10 ± 1.46 * | 38.75 ± 2.89 * | 30.78 ± 2.13 * |
| 5 min e | 59.23 ± 1.73 * | 74.34 ± 2.67 * | 27.91 ± 6.52 * | 26.96 ± 1.39 ** |
| 10 min e | 57.35 ± 1.47 * | 72.06 ± 1.10 * | 19.91 ± 2.73 ** | 22.14 ± 1.50 ** |
| Group | S. mutans a | E. faecalis b | C. albicans c | P. gingivalis d |
|---|---|---|---|---|
| Control | 1244.33 ± 22.24 | 109.00 ± 20.60 ** | 644.00 ± 28.00 | 47.00 ± 13.01 |
| Mixed herbal extracts | 109.00 ± 20.60 ** | 38.33 ± 10.80 ** | 71.00 ± 12.53 ** | 0.00 ± 0.00 ** |
Disclaimer/Publisher’s Note: The statements, opinions and data contained in all publications are solely those of the individual author(s) and contributor(s) and not of MDPI and/or the editor(s). MDPI and/or the editor(s) disclaim responsibility for any injury to people or property resulting from any ideas, methods, instructions or products referred to in the content. |
© 2023 by the authors. Licensee MDPI, Basel, Switzerland. This article is an open access article distributed under the terms and conditions of the Creative Commons Attribution (CC BY) license (https://creativecommons.org/licenses/by/4.0/).
Share and Cite
Yun, S.-E.; Choi, B.-B.r.; Nam, S.-H.; Kim, G.-C. Antimicrobial Effects of Edible Mixed Herbal Extracts on Oral Microorganisms: An In Vitro Study. Medicina 2023, 59, 1771. https://doi.org/10.3390/medicina59101771
Yun S-E, Choi B-Br, Nam S-H, Kim G-C. Antimicrobial Effects of Edible Mixed Herbal Extracts on Oral Microorganisms: An In Vitro Study. Medicina. 2023; 59(10):1771. https://doi.org/10.3390/medicina59101771
Chicago/Turabian StyleYun, Se-Eun, Byul-Bo ra Choi, Seoul-Hee Nam, and Gyoo-Cheon Kim. 2023. "Antimicrobial Effects of Edible Mixed Herbal Extracts on Oral Microorganisms: An In Vitro Study" Medicina 59, no. 10: 1771. https://doi.org/10.3390/medicina59101771
APA StyleYun, S.-E., Choi, B.-B. r., Nam, S.-H., & Kim, G.-C. (2023). Antimicrobial Effects of Edible Mixed Herbal Extracts on Oral Microorganisms: An In Vitro Study. Medicina, 59(10), 1771. https://doi.org/10.3390/medicina59101771

